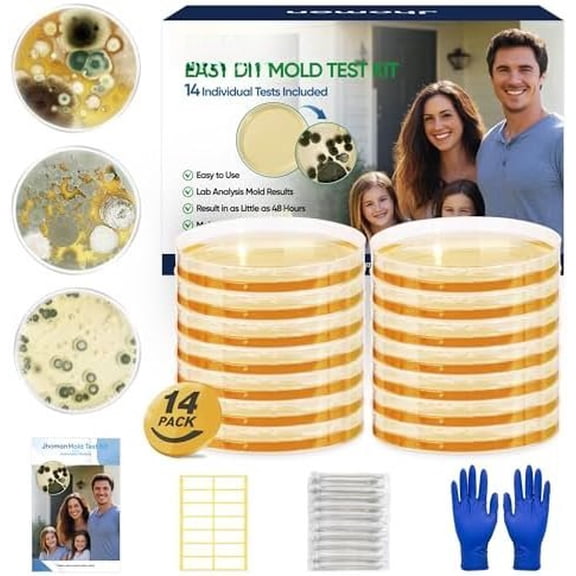
Mold Test Kit for , 14 Simple Mold Detectors with Detailed Mold Guide, DIY Mold Testing Kit for Surfaces & Indoor Air Quality & HVAC & , Results in 48 Hours, 14 count

Ozone Test Kit(7)
Uses item details. Price when purchased online
Clean Vent Air Air Vent Mold Detection Test Kit $19.99

Sponsored
$1999
current price $19.99Clean Vent Air Air Vent Mold Detection Test Kit
54.2 out of 5 Stars. 5 reviews
Mold Test Kit for Home Detection: 8 Simple DIY Science Kits for Fastly Testing Home Surfaces & Air Quality Detector & HVAC Monitor Includes Detailed Identification Guide From $16.99

Sponsored
From$1699
Mold Test Kit for Home Detection: 8 Simple DIY Science Kits for Fastly Testing Home Surfaces & Air Quality Detector & HVAC Monitor Includes Detailed Identification Guide
63.8 out of 5 Stars. 6 reviews
Industrial Test Systems Test Strips,Ozone,0 to 0.5ppm,PK50 481234 $32.88

$3288
current price $32.88Industrial Test Systems Test Strips,Ozone,0 to 0.5ppm,PK50 481234
Ozone Test Paper, Pack Of 12, Results Available After Only 10 Minutes $30.40

$3040
current price $30.40Ozone Test Paper, Pack Of 12, Results Available After Only 10 Minutes
25 out of 5 Stars. 2 reviews
Ozone Detector Ozone Concentration PM2.5PM1.0PM10 Temperature And Humidity TVOC Quality Grade Seven In One $165.65

$16565
current price $165.65Ozone Detector Ozone Concentration PM2.5PM1.0PM10 Temperature And Humidity TVOC Quality Grade Seven In One
Yokua Ozones Detector Analyzer Rechargeable Battery For Indoor Air Quality Monitoring $99.15

$9915
current price $99.15Yokua Ozones Detector Analyzer Rechargeable Battery For Indoor Air Quality Monitoring
Portable Pump Suction Ozone Detector, Oxygen Ammonia Gas VOC Analyzer, Carbon Dioxide Concentration Detector

Portable Pump Suction Ozone Detector, Oxygen Ammonia Gas VOC Analyzer, Carbon Dioxide Concentration Detector
Other options to consider(58)
PRO-LAB Mold Detection Test Kit for Air and Surfaces $12.97

$1297
current price $12.97PRO-LAB Mold Detection Test Kit for Air and Surfaces
1783.9 out of 5 Stars. 178 reviews
Lamotte Water Test Ed Kit,pH,Dis O2,Nitrate,etc 5911 $91.52

$9152
current price $91.52Lamotte Water Test Ed Kit,pH,Dis O2,Nitrate,etc 5911
Ozone Meter,Meter Air With Color Ozone Portable Ozone Meter Screen Adjustable Quality Temperature Temperature With Portable Indoor Indoor Air Lcd Screen Orange $102.46

$10246
current price $102.46Ozone Meter,Meter Air With Color Ozone Portable Ozone Meter Screen Adjustable Quality Temperature Temperature With Portable Indoor Indoor Air Lcd Screen Orange
Mold Test Kit for Home - 12 Simple Detection Tests,Test HVAC System,Home Surfaces,& Indoor Air Quality Testing Kits,DIY Mold Detector at Home,Includes Detailed Mold Identification Guide,air Tester $38.15

$3815
current price $38.15Mold Test Kit for Home - 12 Simple Detection Tests,Test HVAC System,Home Surfaces,& Indoor Air Quality Testing Kits,DIY Mold Detector at Home,Includes Detailed Mold Identification Guide,air Tester
Mold Test Kit for Home, 4 Detection Tests for HVAC, Surfaces & Indoor Air Quality, DIY Black Home Mold Detector Testing kit, Identification Guide & Free Lab Analysis Included $19.99

$1999
current price $19.99Mold Test Kit for Home, 4 Detection Tests for HVAC, Surfaces & Indoor Air Quality, DIY Black Home Mold Detector Testing kit, Identification Guide & Free Lab Analysis Included
Mold Test Kit for ,6 Simple Detection Tests,DIY Indoor Air Quality, Surface & HVAC Analysis,Includes Detailed & Risk Guide

Mold Test Kit for ,6 Simple Detection Tests,DIY Indoor Air Quality, Surface & HVAC Analysis,Includes Detailed & Risk Guide
QwikTest DIY Mold Test Kit for Home Air Quality, Mold Detector Tester for Homeowners Includes Professional Analysis and Customized Lab Reports, All-Inclusive Mold Detection Testing Kit$$Other $61.98

$6198
current price $61.98QwikTest DIY Mold Test Kit for Home Air Quality, Mold Detector Tester for Homeowners Includes Professional Analysis and Customized Lab Reports, All-Inclusive Mold Detection Testing Kit$$Other
Mold Test Kit for , 6 Detection Tests, DIY Black Mold Detector Testing Kit, Indoor Air Quality Testing for HVAC System & Surfaces, Lab Analysis, Guide (6)

Mold Test Kit for , 6 Detection Tests, DIY Black Mold Detector Testing Kit, Indoor Air Quality Testing for HVAC System & Surfaces, Lab Analysis, Guide (6)
Mold Test Kit for by - with 4 Mold Detection + 4 Detection Tests for HVAC, Surfaces, & Indoor Air Quality - DIY Kit inlcudes Detailed Guide & Free Consultation

Mold Test Kit for by - with 4 Mold Detection + 4 Detection Tests for HVAC, Surfaces, & Indoor Air Quality - DIY Kit inlcudes Detailed Guide & Free Consultation
Air Mold Test Kit - Evviva Sciences - 5 Simple Mold Detection Tests - Optional Lab Analysis - Test HVAC System, Room Air, & Home Surfaces - Includes Detailed Mold ID Guide $24.99

$2499
current price $24.99Air Mold Test Kit - Evviva Sciences - 5 Simple Mold Detection Tests - Optional Lab Analysis - Test HVAC System, Room Air, & Home Surfaces - Includes Detailed Mold ID Guide
184.4 out of 5 Stars. 18 reviews
Mold Test Kit for - 12 Simple Detection Tests,Test HVAC System, Surfaces,& Indoor Air Quality Testing Kits,DIY Mold Detector at ,Includes Detailed Mold Guide,air Tester

Mold Test Kit for - 12 Simple Detection Tests,Test HVAC System, Surfaces,& Indoor Air Quality Testing Kits,DIY Mold Detector at ,Includes Detailed Mold Guide,air Tester
Hydrion Quat Test Kit,Wall Mount Quatstart $60.89 Was $74.99

Now$6089
current price Now $60.89, Was $74.99$74.99
Hydrion Quat Test Kit,Wall Mount Quatstart
6 in 1 Quality Monitor Indoor, Pollution Monitor, CO2 Monitor Quality Quality Dete Tester,

6 in 1 Quality Monitor Indoor, Pollution Monitor, CO2 Monitor Quality Quality Dete Tester,
18-in-1 Smart AQI Quality Tester PM Carbon Dioxide Temperature&Humidity Monitor From $35.83

2 options
Available in additional 2 optionsFrom$3583
18-in-1 Smart AQI Quality Tester PM Carbon Dioxide Temperature&Humidity Monitor
21 out of 5 Stars. 2 reviews
Clean Vent Air Air Vent Mold Detection Test Kit $19.99

$1999
current price $19.99Clean Vent Air Air Vent Mold Detection Test Kit
54.2 out of 5 Stars. 5 reviews
OAVQHLG3B Formaldehyde Detector Haze Indoor Air Quality Testing Instrument $46.36

$4636
current price $46.36OAVQHLG3B Formaldehyde Detector Haze Indoor Air Quality Testing Instrument
5 in 1 Air Quality Monitors Indoor Air Quality Meter Rechargeable Tester for CO2

5 in 1 Air Quality Monitors Indoor Air Quality Meter Rechargeable Tester for CO2
EPA-Approved Radon Test Kit for Home, Lab Analysis Included | Detects Radon Gas Levels in Basements & Living Spaces | Easy-to-Use Air Quality Test with Lab Report &Discounted Shipping| Radon Detector $45.88 Was $54.84

Now$4588
current price Now $45.88, Was $54.84$54.84
EPA-Approved Radon Test Kit for Home, Lab Analysis Included | Detects Radon Gas Levels in Basements & Living Spaces | Easy-to-Use Air Quality Test with Lab Report &Discounted Shipping| Radon Detector
Clearance Cevemin Portable Handheld CO2 Air Quality Detector with Temperature and Humidity Monitor - 3-in-1 Multifunctional Carbon Dioxide Tester for Home, Office, Car, RV, and Tent Use Was $29.99

Cevemin Portable Handheld CO2 Air Quality Detector with Temperature and Humidity Monitor - 3-in-1 Multifunctional Carbon Dioxide Tester for Home, Office, Car, RV, and Tent Use
Reduced price 6 In 1 CO2 Detector Formaldehyde Detector Tester Air Quality Monitor for TVOC Was $24.58

6 In 1 CO2 Detector Formaldehyde Detector Tester Air Quality Monitor for TVOC
Air Quality Monitor Indoor CO2 Detector 6-in-1 Air Pollution Carbon Dioxide Detector PM2.5/PM10 Tester

Air Quality Monitor Indoor CO2 Detector 6-in-1 Air Pollution Carbon Dioxide Detector PM2.5/PM10 Tester
UNI-T Uni-trend Gas Leak Detector UT334F Handheld 4 in 1 Air Quality Monitor Carbon Monoxide Detector H2S O2 EX Gas Tester(UT334F) $184.00

$18400
current price $184.00UNI-T Uni-trend Gas Leak Detector UT334F Handheld 4 in 1 Air Quality Monitor Carbon Monoxide Detector H2S O2 EX Gas Tester(UT334F)
Professional Air Quality Tester for CO2, Formaldehyde, TVOC, PM2.5 PM10 PM1.0, Temperature & Humidity, 9-in-1 Meter with Alarm Thresholds $103.83 Was $127.99

Now$10383
current price Now $103.83, Was $127.99$127.99
Professional Air Quality Tester for CO2, Formaldehyde, TVOC, PM2.5 PM10 PM1.0, Temperature & Humidity, 9-in-1 Meter with Alarm Thresholds
Low Level Chlorine Dioxide Test Strips, 0-10 ppm [Vial of 50 Plastic Strips] *NOT FOR POOLS* $19.46
![Low Level Chlorine Dioxide Test Strips, 0-10 ppm [Vial of 50 Plastic Strips] *NOT FOR POOLS*](https://i5.walmartimages.com/seo/Low-Level-Chlorine-Dioxide-Test-Strips-0-10-ppm-Vial-of-50-Plastic-Strips-NOT-FOR-POOLS_b1b55bf0-e222-4711-8c4e-bd035c97389e.5ef0e9e0e2f5dc7165cf53bf10baea8a.jpeg?odnHeight=576&odnWidth=576&odnBg=FFFFFF)
$1946
current price $19.46Low Level Chlorine Dioxide Test Strips, 0-10 ppm [Vial of 50 Plastic Strips] *NOT FOR POOLS*
Mold Test Kit for , 14 Simple Mold Detectors with Detailed Mold Guide, DIY Mold Testing Kit for Surfaces & Indoor Air Quality & HVAC & , Results in 48 Hours, 14 count
Mold Test Kit for , 14 Simple Mold Detectors with Detailed Mold Guide, DIY Mold Testing Kit for Surfaces & Indoor Air Quality & HVAC & , Results in 48 Hours, 14 count
Mosiee 5 In1 Indoor Carbon Dioxide Detector Air Quality Monitor Hcho/Temperature Tester Real-Time Air Quality Monitoring Led Screen

Mosiee 5 In1 Indoor Carbon Dioxide Detector Air Quality Monitor Hcho/Temperature Tester Real-Time Air Quality Monitoring Led Screen
Popular in Shop Portable Ozone Test Kits and Air Quality Monitors for Your Home
Related Products
Ozone Water Tester Meter Portable Tester for Ozone Level in Water Lab Ozone Level Test 220V
Ozone Water Tester Meter Portable Tester for Ozone Level in Water Lab Ozone Level Test 220V$295.00current price $295.00pH Meter,Tester With Water Test 2-in-1 Ph 2-in-1 Ph Temperature Ph Meter Quality Tester With Meter Lcd Water Pen Type Ph Lcd Water Quality Ph Temperature Meter Type Ph Test Rusuo pH-618L
pH Meter,Tester With Water Test 2-in-1 Ph 2-in-1 Ph Temperature Ph Meter Quality Tester With Meter Lcd Water Pen Type Ph Lcd Water Quality Ph Temperature Meter Type Ph Test Rusuo pH-618L$34.87current price $34.87Mold Test Kit for Home Within 2 Individual Tests,Test HVAC,Home Surfaces,Indoor Air Quality Testing Kits,Skin Test,DIY Black Mold Detector Testing kit,Mold Identification Guide-Free Lab Analysis
Mold Test Kit for Home Within 2 Individual Tests,Test HVAC,Home Surfaces,Indoor Air Quality Testing Kits,Skin Test,DIY Black Mold Detector Testing kit,Mold Identification Guide-Free Lab Analysis$16.13current price $16.13Gas tester,Meter Combustible Pen Portable Ppm Meter Handheld Combustible Leak Combustible Leak Natural Leak Natural Tester Natural Tester Portable Tester Portable Ppm Papapi Multicolor HT60
Gas tester,Meter Combustible Pen Portable Ppm Meter Handheld Combustible Leak Combustible Leak Natural Leak Natural Tester Natural Tester Portable Tester Portable Ppm Papapi Multicolor HT60$17.28current price $17.28EASYTEST 19 in 1 Drinking Water Testing Kit 100 Strips + 2 Bacteria Tests - Home Tap and Well Water Test Kit for Hardness, Lead, Iron, Copper, Chlorine, Fluoride
EASYTEST 19 in 1 Drinking Water Testing Kit 100 Strips + 2 Bacteria Tests - Home Tap and Well Water Test Kit for Hardness, Lead, Iron, Copper, Chlorine, Fluoride$14.98current price $14.98gt400 JSP JSP test acid neutralizr 5oz (gt400)
gt400 JSP JSP test acid neutralizr 5oz (gt400)$8.00current price $8.00Mold Test Kit for Home Within 5 Individual Tests,Test HVAC,Home Surfaces,Indoor Air Quality Testing Kits,Skin Test,DIY Black Mold Detector Testing kit,Mold Identification Guide-Free Lab Analysis
Mold Test Kit for Home Within 5 Individual Tests,Test HVAC,Home Surfaces,Indoor Air Quality Testing Kits,Skin Test,DIY Black Mold Detector Testing kit,Mold Identification Guide-Free Lab Analysis$24.63current price $24.63YfiDSJFGJ 2025 All-New 4 in 1 Tds Meter Digital Water Tester, Water Tester for Drinking Water,Portable Multi-Function Digital Water Purity Tester, Water Tester for Drinking 0-9999 ppm
YfiDSJFGJ 2025 All-New 4 in 1 Tds Meter Digital Water Tester, Water Tester for Drinking Water,Portable Multi-Function Digital Water Purity Tester, Water Tester for Drinking 0-9999 ppm$12.74current price $12.7417 in 1 Premium Drinking Water Test Kit - 100 Strips + 2 Bacteria Tests - Home Water Quality Test - Well and Tap Water - Easy Testing for Lead, Bacteria, Hardness, Fluoride, pH, Iron, Copp
17 in 1 Premium Drinking Water Test Kit - 100 Strips + 2 Bacteria Tests - Home Water Quality Test - Well and Tap Water - Easy Testing for Lead, Bacteria, Hardness, Fluoride, pH, Iron, Copp$39.63current price $39.63

















